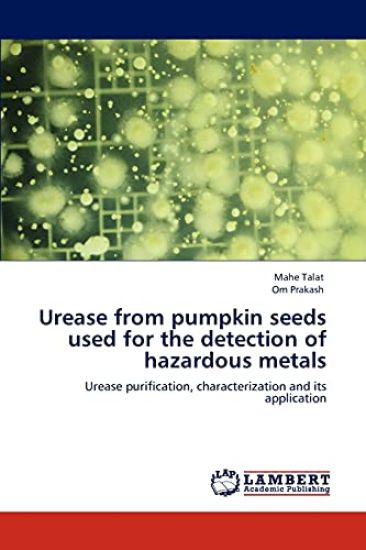
Urease from Pumpkin Seeds Used for the Detection of Hazardous Metals

Urease from Pumpkin Seeds Used for the Detection of Hazardous Metals
Mahe Talat; Omar Prakash Chouhan
Etsi kirjoja tekijän nimen, kirjan nimen tai ISBN:n perusteella.
102 tulosta hakusanalla Mahe-P
Mahe Talat; Omar Prakash Chouhan


Bertrand-François Mahé de la Bourdonnais




A Mahe

A Mahé de la Bourdonnais

Nathalie Mahé

Isabelle Bories-Azeau; Henri Mahé de Boislandelle


A Mahé de la Bourdonnais

S. S. R. M. Mahe Alam Sorwar; Md Tanvir Ahmed; Christopher Wheatley

S. S. R. M. Mahe Alam Sorwar; Md Tanvir Ahmed; Christopher Wheatley

S. S. R. M. Mahe Alam Sorwar; Md Tanvir Ahmed; Christopher Wheatley




Mah-E-Rukh Ahmed

Mah-E-Bushra Asghar; Rubina Bhatti